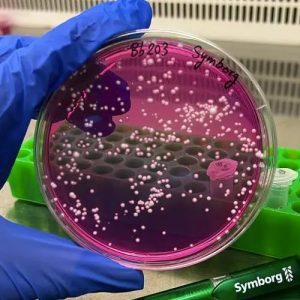

Beauveria bassiana doğada insektisit kontrolünü sağlayan bir fungustur. Ayrıca, dünyanın dört bir yanındaki topraklarda ölü bitki maddesini parçalayarak hayatta kalır. Son araştırmalar, bitkilerle de etkileşime girdiğini, savunmalarını harekete geçirdiğini ve besinleri taşıdığını gösteriyor.
Beauveria bassiana doğada insektisit kontrolünü sağlayan bir fungustur. Ayrıca, dünyanın dört bir yanındaki topraklarda ölü bitki maddesini parçalayarak hayatta kalır. Son araştırmalar, bitkilerle de etkileşime girdiğini, savunmalarını harekete geçirdiğini ve besinleri taşıdığını gösteriyor.
Zararlılara karşı biyoinsektisit kullanımı için AB tarafından onaylanan Beauveria bassiana 203 (Bb203), Symborg’un tarım, ormancılık ve süs bitkilerinde en iyi biyolojik insektisit kontrolü için tercih ettiği türdür.
